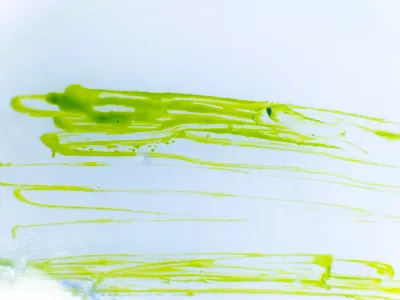
DSCF6362.webp

Фотосинтезирующие водоросли являются первичными продуцентами в водоемах и находятся в начале трофических цепей. Их гибель приводит к подрыву кормовой базы других обитателей водоемов и в конечном счете может вызвать необратимое сокращение разнообразия водного биоценоза. Также водоросли выделяют кислород важный для большинства обитателей водных экосистем и потребляют углекислый газ, участвуя тем самым в нейтрализации парникового эффекта.
В ходе испытаний используется ГОСТ 32293-2013 «Испытание водорослей и цианобактерий на задержку роста» (OECD, Test No. 201, IDT). Срок выполнения работ — 2 недели